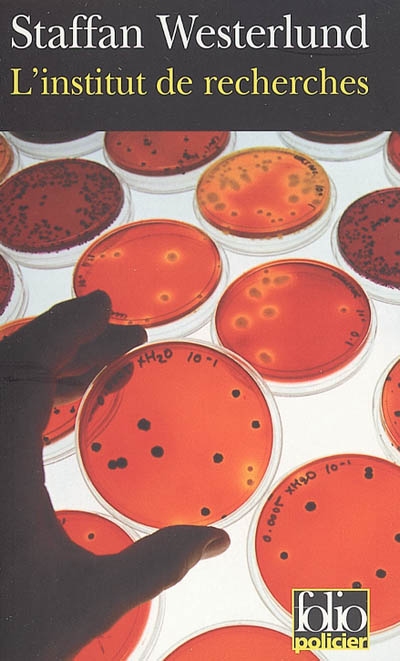
L'Institut de recherches - STAFFAN WESTERLUND

|
|
|
|
|
L'Institut de recherches
STAFFAN WESTERLUND
| 16,95 $
|
|
|
|
 Feuilleter
|
Sur commande : 2 à 4 semaines
INFORMATION
Votre colis partira de notre entrepôt d’ici 10 à 20 jours ouvrables, ce qui exclut les week-ends et les jours fériés. La date de livraison dépendra ensuite du délai d'acheminement de la poste, qui varie selon la destination. Pour une livraison au Québec, le délai habituel est de un à trois jours.
|
|
|
|
Ajouter à ma liste de souhaits
|
|
|
L'Institut de recherches
de
WESTERLUND, STAFFAN
| Centre les Rivières |
4225, boulevard des Forges local P13
Trois-Rivières
G8Y 1W2 |
819-376-7227 |
0 |
Heures
d'ouverture |
Pour s'y rendre |
| Chicoutimi |
1120, boulevard Talbot
Chicoutimi
G7H 7R2 |
418-698-1586 |
0 |
Heures
d'ouverture |
Pour s'y rendre |
| St-Romuald |
1238 rue de la Concorde
Saint-Romuald
G6W 0M7 |
418-903-1095 |
0 |
Non
disponible |
|
| Jean-Talon |
250 Jean Talon Est
Montréal
H2R 1S7 |
438-387-1091 |
0 |
Non
disponible |
|
| Lebourgneuf |
1580 boul. Lebourgneuf
Québec
G2K 2M4 |
418-380-8118 |
0 |
Heures
d'ouverture |
Pour s'y rendre |
| Place des Arts |
1501 rue Jeanne-Mance
Montréal
H2X 1Z8 |
514-281-0367 |
0 |
Heures
d'ouverture |
Pour s'y rendre |
| Ste-Dorothée |
520, Autoroute Chomedey
Laval
H7X 3S9 |
450-719-2020 |
0 |
Lu Mar Mer
9h00 à 21h00
Je Ven
9h00 à 21h00
Samedi
9h00 à 18h00
Dimanche
10h00 à 18h00 |
Pour s'y rendre |
| Ste-Foy |
2450, boul. Laurier, local M26
Québec
G1V 2L1 |
418-653-2387 |
0 |
Lu Mar Mer
6h00 à 21h00
Je Ven
9h00 à 21h00
Samedi
9h00 à 21h00
Dimanche
9h00 à 21h00 |
Pour s'y rendre |
| Mail Champlain |
2151, boul. La Pinière
Brossard
J4W 2T5 |
450-671-7654 |
0 |
Lu Mar Mer
9h00 à 21h30
Je Ven
9h00 à 21h30
Samedi
9h00 à 21h00
Dimanche
9h00 à 18h00 |
Pour s'y rendre |
| Carrefour Angrignon |
7077, Boul. Newman local 00120
Ville Lasalle
H8N 1X1 |
514-365-2587 |
0 |
Heures
d'ouverture |
Pour s'y rendre |
| Avenue du Parc |
5117, avenue du Parc
Montreal
H2V 4G3 |
514-276-7651 |
0 |
Heures
d'ouverture |
Pour s'y rendre |
| Beauport |
3333 rue du Carrefour local 158
Québec
G1C 5R9 |
581-742-3200 |
0 |
Heures
d'ouverture |
Pour s'y rendre |
| Saint-Bruno |
205 boulevard des Promenades
St-Bruno de Montarville
J3V 5K3 |
450-653-0546 |
0 |
Heures
d'ouverture |
Pour s'y rendre |
| Brossard |
6925, boul. Taschereau
Brossard
J4Z 1A7 |
450-443-5350 |
0 |
Heures
d'ouverture |
Pour s'y rendre |
| Centre Laval |
1600, boul. le Corbusier #109
Laval
H7S 1Y9 |
450-682-2587 |
0 |
Heures
d'ouverture |
Pour s'y rendre |
| Champigny Saint-Denis |
4380, rue St-Denis
Montréal
H2J 2L1 |
514-844-2587 |
0 |
Heures
d'ouverture |
Pour s'y rendre |
| Complexe Desjardins |
C.P. 393 150, rue Ste-Cath.O - local #113
Montréal
H5B 1B5 |
514-288-4844 |
0 |
Heures
d'ouverture |
Pour s'y rendre |
| Vaudreuil-Dorion |
54, Blvd De la Cité des Jeunes Local 100
Vaudreuil-Dorion
J7V 9L5 |
450-218-0571 |
0 |
Heures
d'ouverture |
Pour s'y rendre |
| Plaza St-Hubert |
6255 rue Saint-Hubert
Montréal
H2S 2L9 |
514-288-0952 |
0 |
Heures
d'ouverture |
Pour s'y rendre |
| Boisbriand |
3220 Av. des Grandes Tourelles, Faubourg Boisbriand
Boisbriand, QC
J7H 0A2 |
579-979-6888 |
0 |
Heures
d'ouverture |
Pour s'y rendre |
| Fleury |
1691, rue Fleury Est
Montréal
H2C 1T1 |
514-384-9920 |
0 |
Heures
d'ouverture |
Pour s'y rendre |
| Gatineau |
1100, Boul. Maloney Ouest
Gatineau
J8T 6G3 |
819-243-9700 |
0 |
Heures
d'ouverture |
Pour s'y rendre |
| Place Longueuil |
825 rue Saint-Laurent Ouest Local : 144
Longueuill, QC
J4K 2V1 |
579-881-1402 |
0 |
Heures
d'ouverture |
Pour s'y rendre |
| Granby |
50-2 rue Simonds Nord
Granby
J2J 2L1 |
450-375-0699 |
0 |
Heures
d'ouverture |
Pour s'y rendre |
| Saint-Jérome |
900, boul. Grignon local # 60
St-Jérôme
J7Y 3S7 |
450-432-9100 |
0 |
Heures
d'ouverture |
Pour s'y rendre |
| Pointe-Claire |
6815, Route Transcanadienne, Local C001
Pointe-Claire
H9R 1C4 |
514-782-1222 |
0 |
Heures
d'ouverture |
Pour s'y rendre |
| Rosemère |
382 boul. Labelle
Rosemère
J7A 3R8 |
450-434-0202 |
0 |
Heures
d'ouverture |
Pour s'y rendre |
| Carrefour Laval |
3035 Boulevard Le Carrefour Local SR24B
Laval
H7T 1C8 |
450-681-3032 |
0 |
Heures
d'ouverture |
Pour s'y rendre |
| Drummondville |
520 boul Saint-Joseph
Drummondville
J2C 2B8 |
819-850-2000 |
0 |
Heures
d'ouverture |
Pour s'y rendre |
| St-Georges de Beauce |
8540, Boulevard Lacroix
St-Georges de Beauce
G5Y 2B5 |
418-227-3182 |
0 |
Heures
d'ouverture |
Pour s'y rendre |
| Côte-des-Neiges |
5252, chemin Côte-des-Neiges
Montréal
H3T 1X8 |
514-342-1515 |
0 |
Heures
d'ouverture |
Pour s'y rendre |
| Repentigny |
100 Boul. Brien Ouest, local 158b
Repentigny
J6A 5N4 |
450-932-6892 |
0 |
Heures
d'ouverture |
Pour s'y rendre |
| Trois-Rivières |
3275, Boul des Récollets
Trois-Rivières
G9A 6M1 |
819-840-2624 |
0 |
Heures
d'ouverture |
Pour s'y rendre |
| Centre Rockland |
2305 Chemin Rockland
Mont-Royal
H3P 3E9 |
514-543-5221 |
0 |
Heures
d'ouverture |
Pour s'y rendre |
| Place du Royaume |
1401 boulevard Talbot local #170
Chicoutimi
G7H 5N6 |
581-654-1127 |
0 |
Heures
d'ouverture |
Pour s'y rendre |
| Carrefour l'Estrie |
3050, boul. Portland - local N-11
Sherbrooke
J1L 1K1 |
819-569-9957 |
0 |
Heures
d'ouverture |
Pour s'y rendre |
| St-Jean-sur-Richelieu |
927 Boulevard Séminaire Nord
Montréal
J3A 1B5 |
579-381-1110 |
0 |
Non
disponible |
|
| Sorel |
450, boul. Poliquin - Local 102
Sorel
J3P 7R5 |
450-746-8771 |
0 |
Heures
d'ouverture |
Pour s'y rendre |
| Les Galeries de Terrebonne |
1185, boul. Moody Local 081
Terrebonne
J6W 3Z5 |
450-492-1011 |
0 |
Heures
d'ouverture |
Pour s'y rendre |
| Lévis |
1200 Alphonse-Desjardins #0120
Lévis
G6V 6Y8 |
418-837-5538 |
0 |
Heures
d'ouverture |
Pour s'y rendre |
| Galeries d Anjou |
7999, boul. Les Galeries d'Anjou
Ville d'Anjou
H1M 1W6 |
514-353-2353 |
0 |
Heures
d'ouverture |
Pour s'y rendre |
| Victoriaville |
1111, boul. Jutras Est - Local 1
Victoriaville
G6S 1C1 |
819-357-4878 |
0 |
Heures
d'ouverture |
Pour s'y rendre |
| Place Ville Marie |
1 Place Ville-Marie, local 11170
Montréal, QC
H3B 2C4 |
514-552-9649 |
0 |
Heures
d'ouverture |
Pour s'y rendre |
|
|
|
|
EN SAVOIR PLUS
Résumé
L'institut de recherches
Une enquête d'Inga-Lisa Östergren. Traduit du suédois par Philippe Bouquet . Un corps retrouvé au large des côtes suédoises par des pêcheurs et qui a disparu le lendemain lorsque la police vient le chercher... Des maisons en principe vides appartenant à deux chercheurs du même institut, et qui brûlent simultanément avec leurs neuf occupants... Une journaliste retrouvée recroquevillée sur un îlot, morte d'un cancer, avec autour d'elle les cadavres de trois hommes armés... Drôle de Suède ! Inga-Lisa Östergren, soeur de la dernière victime, ne compte pas en rester là. Secrète et déroutante, totalement atypique et d'un pragmatisme inflexible, la jeune femme va vite se retrouver au coeur d'un incroyable secret....
Détails
|
Prix :
|
16,95 $
|
|
Catégorie :
|
|
|
Auteur :
|
STAFFAN WESTERLUND
|
|
Titre :
|
L'Institut de recherches
|
|
Date de parution :
|
février 2005
|
|
|
|
|
|
Éditeur :
|
GALLIMARD
|
|
Collection :
|
FOLIO POLICIER
|
|
|
|
Sujet :
|
ROMAN POLICIER
|
|
ISBN :
|
9782070314171 (20703141711)
|
|
Référence Renaud-Bray :
|
399922511
|
|
|
|
No de produit :
|
618677
|
L'Institut de recherches
,
WESTERLUND, STAFFAN
©
GALLIMARD
2005
|
|
1449 article(s) au panier.
Renaud-Bray vous offre
les frais de livraison *
|